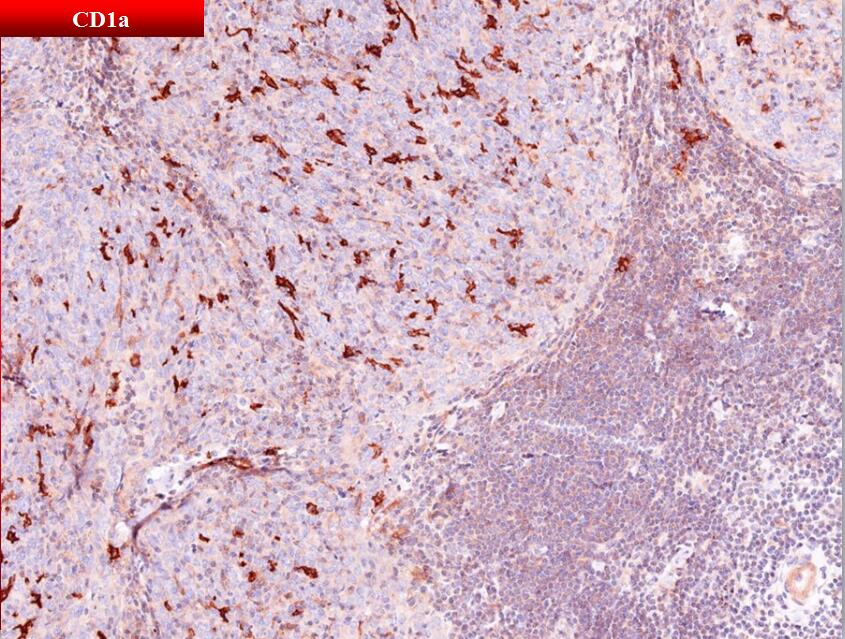

男性,50岁,发现纵膈肿物2周余入院,否认眼睑下垂、四肢乏力、咳嗽、咳痰、咯血等症状
胸部增强CT:前纵膈内主动脉前方见类圆形软组织密度影,大小2.5X2.1cm。胸腔镜辅助下纵膈肿物+胸腺切除术。
大体所见:蝶形软组织,大小8X9X2cm,前表面光滑,后表面粗糙,切面大部分为脂肪,胸腺器官结构难以辨识,脂肪组织内见一大小2.5X2.0X2.5cm的结节,距后表面剥离面0.1cm,距最近软组织切缘2.5cm,与周围分界清楚,无包膜,切面灰白、实性、分叶状,质脆。
病理诊断:
特殊类型胸腺瘤,具有伴淋巴间质的微结节型胸腺瘤的结构和间质,B3型胸腺瘤的细胞特点,以及胸腺癌的免疫表型。
Comment:该肿瘤的组织形态代表了伴淋巴间质的微结节型胸腺瘤的非典型变型or B3型胸腺瘤甚或胸腺癌的微结节变型尚不清楚。预后评估请重点参考病理分期及切缘评估。
病理学分期:Mosaoka Staging I期、TNM Staging I 期
切缘评估:距离后表面切缘3mm,最近侧切缘大于1cm
伴淋巴间质的微结节型胸腺瘤Micronodular thymoma with lymphoid stroma(MTWLS)
定义(2015 年版WHO胸腺肿瘤分类):是一种胸腺上皮性肿瘤,由多量小的上皮性肿瘤结节和无上皮细胞的淋巴间质组成。
组织形态学特点:
无上皮细胞的淋巴间质
组织结构:可见淋巴滤泡,伴或不伴生发中心形成
细胞组成:丰富的淋巴细胞和数量不等的浆细胞;淋巴细胞具有与其它类型胸腺瘤迥异的免疫表型;淋巴间质主体- CD20+/CD79α+的成熟B细胞&CD3+ /TdT-的成熟T细胞;肿瘤结节周边-带状分布CD3+/CD1α+/CD99+/TdT+的不成熟T细胞。
肿瘤结节
细胞组成:上皮细胞组成结节主体;散在分布少量TdT+的不成熟T细胞;弥漫分布多量 CD1α+/Langerin+的Langerhans细胞。
组织结构:微囊或巨囊性改变较常见,可见玫瑰花环状或腺样结构,缺乏胸腺小体、血管周间隙以及分叶状结构。
细胞形态:卵圆形或短梭形,胞浆稀少,核形较一致,卵圆形或长圆形,形态温和,染色质分散,核仁不明显,缺乏核分裂像或核分裂象极少。
免疫表型
阳性: pan-Cytokeratin、CK5/6、CK19
阴性:CD20、CD5、CD117
本病例与经典MTWLS相同和不同之处
思考:具有MTWLS的结构和间质特点的胸腺上皮性肿瘤
一组明显异质性的肿瘤
肿瘤细胞形态
低级别:经典MTWLS
高级别:类似A、AB、B1-3甚至胸腺癌的病例均有报道
预后
交界性:经典型MTWLS
不明:各不相同,但总体比形态上相似的经典型胸腺瘤/胸腺癌好
诊断时,不可仅仅根据结构和间质特点就草率地归入经典型MTWLS,而应该对肿瘤结节的特点进行仔细分析和报告.
大宗临床研究显示:胸腺上皮性肿瘤的预后主要由肿瘤分期和切除情况决定,WHO组织学分型是否能做为独立的预后因素仍存在争议,尤其对特殊类型的胸腺瘤更知之甚少。病理报告应提供详细的分期和切缘信息供临床参考。
胸腺瘤/胸腺癌病理分期:
Masaoka-Koga staging
TNM Staging
7th AJCC Cancer Staging Manual 没有推荐用于胸腺瘤/胸腺癌的分期系统
2014 IASLC/ITMIG推荐胸腺瘤/胸腺癌TNM,将被收入8th AJCC Cancer Staging Manual Staging
是一个基于全球多地区、多中心、多学科联合临床研究的大宗数据分析基础上,迄今为止与胸腺上皮性肿瘤预后相关性最好的分期系统。


参考文献
l William D. Travis, Elisabeth Brambilla, Allan P. Burke, et al. WHO Classification of Tumor of Lung, Pleura, Tymus and Hear. Lyon, 2015, IARC: 205-206
l Yoshinori Ishikawa, Hisashi Tateyama, Megumi Yoshida, et al. Micronodular thymoma with lymphoid stroma: an immunohistochemical study of the distribution of Langerhans cells and mature dendritic cells in six patients. Histopathology 2015, 66: 300–307
l Annikka Weissferdt, Cesar A Moran. Micronodular thymic carcinoma with lymphoid hyperplasia: a clinicopathological and immunohistochemical study of five cases. Modern Pathology 2012, 25: 993–999
l H Tateyama, Y Saito, Y Fujii, M, et al. The spectrum of micronodular thymic epithelial tumours with lymphoid B-cell hyperplasia. Histopathology 2001, 38:519-527
l Anja C. Roden, Eunhee S. Yi, Sarah M. Jenkins. Modified Masaoka Stage and Size Are Independent Prognostic Predictors in Thymoma and Modified Masaoka Stage Is Superior to Histopathologic Classifications. Journal of Thoracic Oncology 2015, 10 (4): 691-700
l Kondo K, Van Schil P, Detterbeck FC , et al. The IASLC/ITMIG Thymic Epithelial Tumors Staging Project: proposals for the N and M components for the forthcoming (8th) edition of the TNM classification of malignant tumors. J Thorac Oncol 2014, Sep, 9(9 Suppl 2):S81-7
l Anja C. Roden, Eunhee S. Yi, Sarah M. Jenkins. Reproducibility of 3 Histologic Classifications and 3 Staging Systems for Thymic Epithelial Neoplasms and Its Effect on Prognosis. Am J Surg Pathol 2015, 39 (4): 427-441